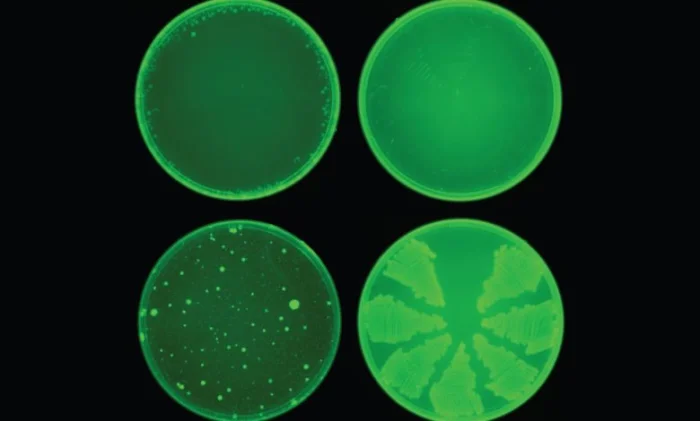
Ученые открывают мощный антибиотик, используя модель глубокого обучения

Ученые открывают мощный антибиотик, используя модель глубокого обучения
Используя искусственный интеллект, исследователи обнаружили мощный антибиотик под названием Халицин. Он убивает вредные бактерии, в том числе устойчивые ко всем существующим антибиотикам. Он имеет химическую структуру, отличную от всех известных антибиотиков, и использует другой подход для уничтожения бактерий.
Открытие пенициллина (первого антибиотика) произвело революцию в медицине в 20 веке. Однако за последние несколько десятилетий разработка антибиотиков значительно сократилась.
Открытые в последние годы антибиотики — это лишь слегка отличающиеся друг от друга версии существующих лекарств. Биологи приложили огромные усилия, чтобы проверить обитающие в почве микробы на наличие признаков, которые, как известно, убивают смертоносные бактерии.
Но поскольку супербактерии, устойчивые к современным антибиотикам, получили широкое распространение, ученые не смогли добиться серьезных прорывов. Кроме того, существующие методы скрининга новых антибиотиков требуют значительных временных и финансовых вложений и зачастую ограничены химическим разнообразием.
Теперь искусственный интеллект помогает биологам просматривать большие базы данных молекул, которые сильно отличаются от существующих антибиотиков. Недавно исследователи из Массачусетского технологического института использовали новый алгоритм машинного обучения для анализа огромного цифрового архива, содержащего более 100 миллионов химических соединений, и выявления тех, которые могут убить многие из наиболее проблемных бактерий, вызывающих заболевания в мире.
Они обнаружили новый мощный антибиотик, который убивает вредные бактерии, в том числе устойчивые ко всем существующим антибиотикам.
Они использовали модель глубокого обучения (все более популярное подмножество метода машинного обучения) для обнаружения антибиотиков, которые используют различные подходы по сравнению с существующими лекарствами, чтобы убить бактерии.
В дополнение к этому новому антибиотику, модель смогла выявить еще 23 перспективных кандидата на антибиотики, которые имеют различные структуры по сравнению с существующими препаратами и предсказывают нетоксичность для клеток человека.
Модель может анализировать большие химические пространства, которые, как правило, требуют много времени и дорогостоящих исследований с помощью обычных экспериментальных методов. По словам исследовательской группы, модель многое узнала о химической структуре на своем этапе обучения, поэтому она также может быть использована при разработке новых лекарств.
Халицин: Мощный антибиотик
Модель отображает молекулы в непрерывные векторы, которые отражают отсутствие или присутствие определенных химических групп. Эти векторы впоследствии используются для оценки свойств соединений.
Команда обучила свою модель почти на 2500 молекул для поиска свойств, которые делают молекулы эффективными при убийстве кишечной палочки. Обучившись, они протестировали модель на 6000 соединениях из центра по переработке лекарств Broad Institue’s Drug Repurposing Hub.
Обученные нейронные сети обнаружили одну молекулу, которая, по оценкам, обладает очень эффективными антибактериальными свойствами, низкой токсичностью по отношению к клеткам человека и химической структурой, отличной от всех существующих антибиотиков.
Исследователи назвали его Халицин, в честь системы искусственного интеллекта из научно-фантастического фильма «Космическая одиссея 2001 года». Они протестировали эту молекулу против нескольких выращенных в лаборатории бактериальных штаммов. Он работал против большинства видов, которые они тестировали, включая бактерии, которые стали устойчивыми ко всем известным антибиотикам.
Команда также тестировала Халицин в двух различных моделях мышей. Она смогла полностью избавиться от инфекций в течение 24 часов.
Более впечатляющим является то, что у кишечной палочки не развилась устойчивость к этому новому препарату в течение месяца лечения. Для сравнения: бактерии начинают вырабатывать устойчивость к существующему антибиотику под названием ципрофлоксацин в течение одного дня, а через месяц он становится в 200 раз более устойчивым.
В ближайшие годы исследователи будут работать с фармацевтическими компаниями или некоммерческими организациями для дальнейшего изучения Халицина и разработки его для использования на людях.
Источник